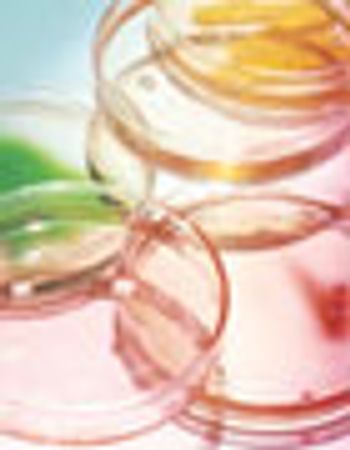

The HSV-1 and HVP-2 titers were determined by the inoculation of test solutions into Vero cell cultures and calculated using the Reed M?ench method.
The HSV-1 and HVP-2 titers were determined by the inoculation of test solutions into Vero cell cultures and calculated using the Reed M?ench method.

Development guidelines for MAbs serve as a blueprint for their manufacture, safety, and efficacy testing.

Published: February 1st 2006 | Updated:

Published: January 1st 2007 | Updated: